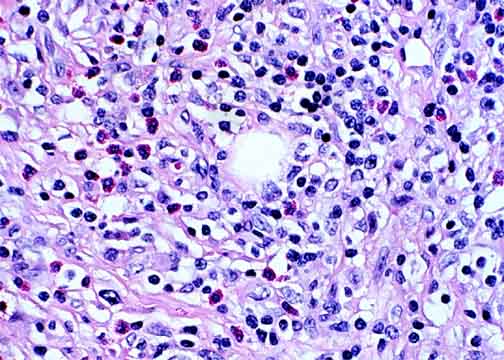
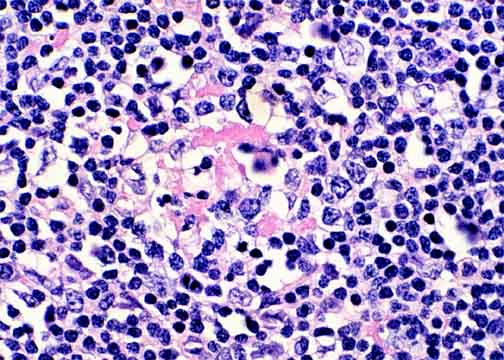

Go to:

TOC
|
Peripheral T-Cell Lymphomas: Example 4B
This is a more advanced form of the skin PTCL-NOC seen in Case 4A.

The lymphoma in this lymph node is very fibrotic. It has clusters of
smaller lymphoid cells and a mixed infiltrate between them.
|
The fine sclerosis surrounds both atypical, malignant T-cells and a
reactive inflammatory accompaniment including eosinophils.
|
In one of the clusters of smaller cells, large, atypical T-cells are
also present.
|
Table of Contents
|